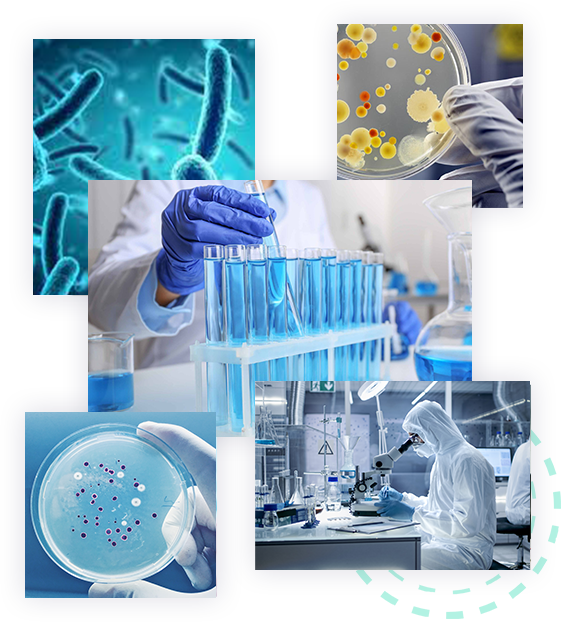

Trung tâm Giống và Bảo tồn nguồn gen Vi sinh vật
Giới thiệu
Trung tâm Giống và Bảo tồn nguồn gen Vi sinh vật (VCCM)
VCCM lưu giữ và cung cấp một lượng lớn đa dạng nguồn gen vi sinh vật có giá trị phục vụ cho nghiên cứu, đào tạo, ứng dụng và thương mại hóa các sản phẩm sinh học từ vi sinh vật trong các ngành công nông lâm ngư nghiệp, y dược, an ninh quốc phòng và bảo vệ môi trường
Thành tựu VCCM
1
+
Chủng vi sinh vật
1
+
Công trình nghiên cứu
1
+
Đối tác
1
+
Chuyên gia












